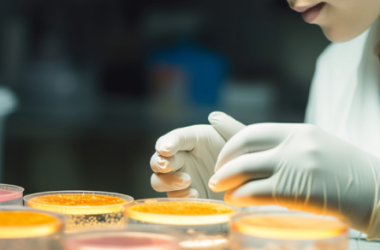
引入“时间维度”后，AI将迎来怎样的变革？-Ai设计师学院

中新网上海3月2日电 (记者 陈静)人工智能时代,医学教育应该怎样设计、开展?全国人大代表、中国工程院院士、上海交通大学医学院院长范先群表示,在即将举行的十四届全国人大三次会议上,他将聚焦这个话题:“应该有所加、有所减”。
“医学本身就是更新很快的学科,如今,新技术不断涌现,医学生要学的东西越来越多,医学知识、医学人文以及包括计算机、人工智能在内的交叉学科知识都不可少。”他说。
“可是人的时间是有限的,如何把时间还给学生,这需要医学教育工作者思考。一些已经被攻克并消灭的病症,比如沙眼,就不用医学生花太多精力去学习了。”范先群说,上海交通大学大医学院今年率先提出“4+4+X”医工交叉本博贯通MD(医学博士)+PhD双学位创新人才培养。这种培养模式突破传统思路,深刻分析人工智能时代满足未来健康医疗需求的医工交叉领军人才的培养要素,可为中国顶尖医学人才培养探索新路径;同时通过科研和临床的“双轮驱动”,可以培养一批医工交叉领域的领军人物。
作为一名医务工作者、教育工作者、眼科专家,范先群把履职和日常工作紧密结合起来。在十四届全国人大一次和二次会议上,他关注医学生实习的待遇保障、近视防控需要全生命周期管理、健全老年人健康服务体系等问题。
范先群院士把履职和日常工作紧密结合起来,同时在工作中推进相关问题的解决。(受访者供图)
范先群特别重视青少年的眼健康。他在《亚太眼科杂志》上发表的论文题目就是《全生命周期近视管理》。他调查了全国5个区域逾5万名小学生,获得了大量数据,希望通过综合的近视防控方法,借助人工智能管理,更好地预防近视。
随着中国老龄化进程加速,范先群也持续关注“健康老龄化”议题。在他看来,通过构建完善的老年人健康服务体系推进健康老龄化,既是应对人口老龄化最具成本效益的解决方案,又是提升2.8亿老年人生活质量的核心路径。范先群说:“实现每位老年人享有高质量健康服务的目标,不单是保障老年群体福祉的必然要求,更是实现健康老龄化的重要基石。”(完)

评论前必须登录!
注册